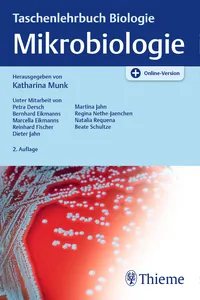
Munk, TLB Mikrobiologie, A2, ePub_cover

Thieme
1 - 60 von 241 Büchern werden angezeigt

Schumpelick, Hernien, A5, ePubVolker Schumpelick, Georg Arlt, Klaus Joachim Conze, Karsten Junge
2015

Schumpelick, Hernien, A5, ePub
Volker Schumpelick, Georg Arlt, Klaus Joachim Conze, Karsten Junge
2015

Meybohm, Fehler in der Anästh., A2, ePub
Patrick Meybohm, Michael St.Pierre, Wolfgang Heinrichs, Berthold Bein
2016

Huber, Motorisches Lernen Neuroreha, A1, ePub
Martin Huber, Christina Janssen, Florian Erzer Lüscher, Gail Andrea Cox Steck
2022